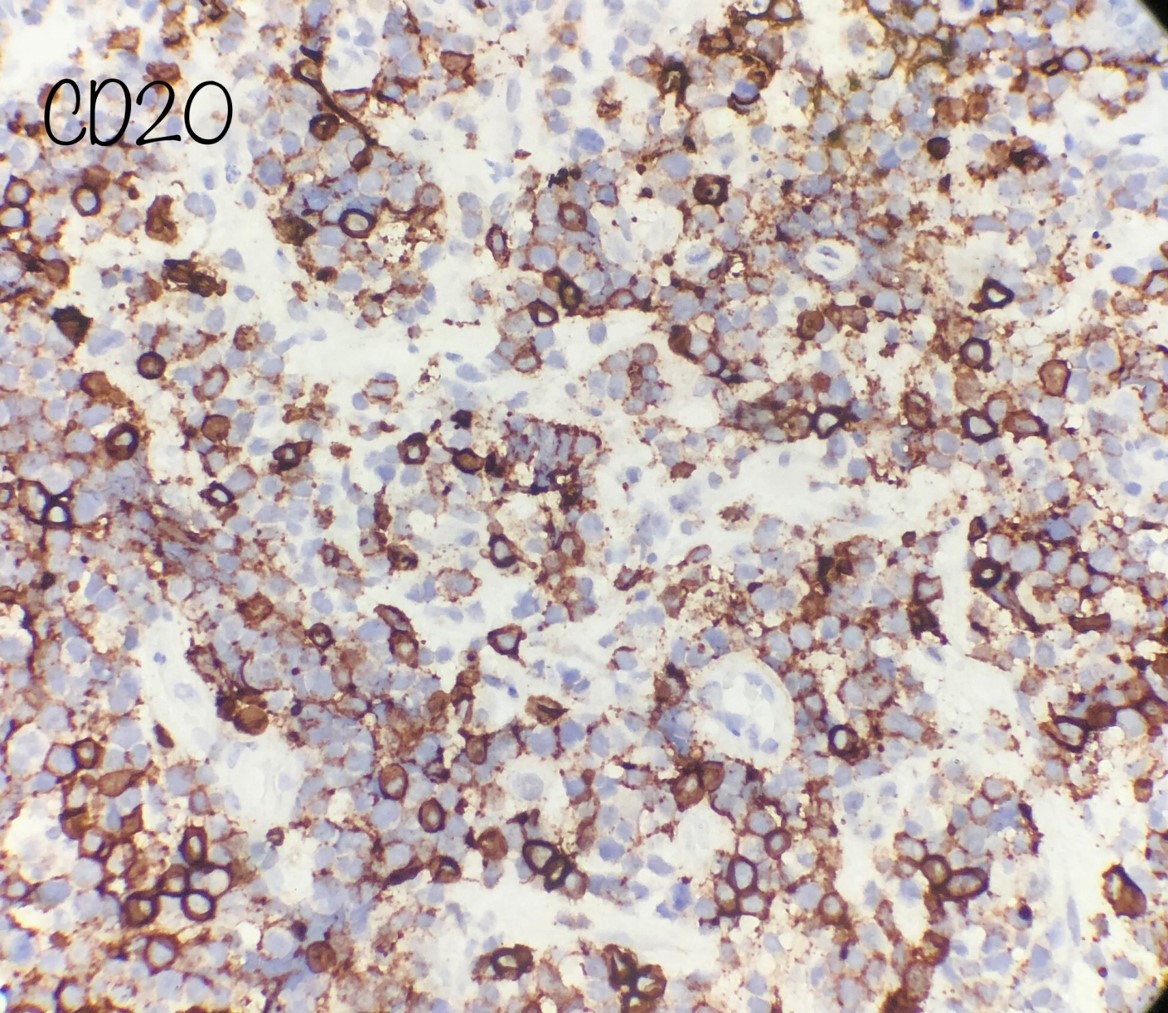

Case History
56-year-old with a left temporal brain tumor.
What is the diagnosis?
- Metastatic small cell carcinoma
- Glioblastoma, WHO Grade IV
- Diffuse large B-cell lymphoma of the CNS, germinal center type
- Anablastic Meningioma, WHO grade III

Answer: C. Diffuse large B-cell lymphoma of the CNS, germinal center type
Discussion:
H&E and CD20 exhibit a diffuse large b cell neoplasm of the CNS (categorized within the primary central nervous system lymphomas)
More than 60% involve the supratentorial space with most sites in the cerebral hemispheres with ocular involvement present in 15-20% of cases.
Up to 85% can be seen within immunocompromised
They can be seen as discohesive cells with large round to irregular nuclei with a high proliferative index (our case was up to 90%).
Germinal center type was identified following the Hans criteria
Case contributed by: Michael Williams, M.D., M.Sc., Neuropathology Fellow, UAB Pathology